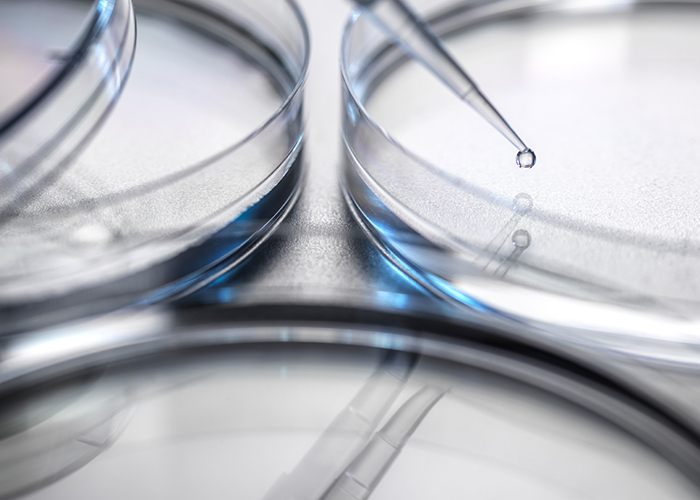
img

인사말
不二
둘이 아닌 하나가 되는 치유의 공간
암환자와 병원 의료진이 “不二”
즉, 둘이 아닌 하나가 되는 강남세종한방병원에
오신 것을 진심으로 환영합니다.
10년 전 암을 정복하겠다는 일념으로
줄기세포, 침, 부항 등의 한방치료를 임상과 연구에 매진하며
암환자들과 함께했던 시간들이 있습니다.
그 시절의 열정과 노력이 지금은 소중한 자양분이 되어
수많은 환자분들을 진료하는 밑거름이 되었습니다.
공포와 두려움으로 나약해진 환자의 마음을
삶의 의욕으로 바꾸고, 믿고 신뢰하는 치료와 면역 관리를 통해
조금씩 조금씩 밝은 얼굴이 되어가는 기쁨을 함께 누리며
하루하루 최선을 다하고 있습니다.
강남세종 진료철학

전문성 있는 진료
줄기세포 치료, 침술, 부항 등 한방 치료의 깊이 있는 임상 연구를 바탕으로 암 치료에 특화된 전문성을 갖추고 있습니다.
10년간의 축적된 데이터와 경험은 환자 한 분 한 분에게 최적화된 치료법을 제시할 수 있는 근거가 됩니다.
암 면역치료 전문 프로그램 운영
줄기세포 및 한방 통합 치료 연구
개별 맞춤형 치료 계획 수립
지속적인 임상 연구와 학술 활동
의료진이 직접 책임지는 진료
강남세종한방병원은 모든 의료진이 직접 진료·직접 상담을 원칙으로 합니다.
시스템에 의존한 형식적인 진료가 아닌, 의료진이 1:1로 환자를 마주하며 질환의 원인과 생활, 심리 상태까지 세심하게 살피는 진료를 실천합니다. 환자와의 신뢰를 가장 중요한 치료의 출발점으로 생각합니다.
의료진 전원 직접 상담 및 직접 진료
환자 상태를 충분히 듣는 1:1 맞춤 진료
치료 전·중·후 일관된 의료진 관리
환자와 보호자가 이해할 수 있는 설명 중심


마음을 치유하는 진료
암 진단은 신체적 고통을 넘어 삶 전반에 큰 흔들림을 줍니다. 질환 치료 뿐 아니라 불안과 두려움으로 지친 마음을 회복시키는 것을 진료의 중요한 가치로 삼고 있습니다. 따뜻한 공감과 진심 어린 소통을 통해 환자가 다시 삶의 의지를 되찾을 수 있도록 함께합니다.
심리적 안정과 희망 회복에 중점
환자 및 가족을 위한 정서적 지지
긍정적인 회복 마인드 형성
치료 여정을 함께하는 지속적인 격려
강남세종 진료철학
현장에서 직접 귀 기울이는 진료
강남세종한방병원의 가장 큰 차별점은 원장을 비롯한 의료진이 직접 환자를 진료하며,
진료실을 넘어 간호 현장과 식사 시간 등 병원 곳곳에서 환자의 목소리에 귀 기울인다는 점입니다.
많은 병원들이 시스템화·분업화된 구조로 운영되는 반면,
저희는 의료진이 환자의 일상 속으로 직접 들어가
작은 불편함과 변화까지 세심하게 살피는 진료를 실천합니다.
이를 통해 치료 과정에서 놓치기 쉬운 중요한 신호들을 발견하고,
즉각적으로 치료 계획에 반영합니다.
환자의 회복은 진료실 안에서만 이루어지지 않습니다.
식사, 수면, 일상적인 활동까지 병원 생활의 모든 순간이 치유의 과정이기에,
저희 의료진은 환자와 전 과정을 함께하며 삶의 질을 높이는 전인적인 치료를 실현합니다.